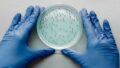

性病の早期発見と治療:マイコプラズマの症状と重要性
マイコプラズマは、性的接触を通じて感染することがある性病の一種です。本記事では、マイコプラズマ感染の具体的な症状や感染経路、早期発見と治療の重要性に焦点を当て、読者に性病検査の重要性と性病検査 STDチェッカーの活用を啓発します。正確な知識を得て、マイコプラズマ感染への意識を高めましょう。
マイコプラズマ感染の症状
マイコプラズマ感染は、しばしば無症状であることがあります。しかし、感染している人の一部では以下のような症状が現れることがあります。
- 尿路感染症状: 尿道炎や膀胱炎のような尿路感染症状が生じることがあります。頻尿、排尿時の痛み、尿の異常な臭いや色の変化が見られる場合があります。
- 生殖器感染症状: 生殖器部分の炎症や異常分泌物が生じることがあります。女性では、腟炎や子宮頸管炎の症状が見られることがあります。具体的には、かゆみ、腫れ、痛み、異常な分泌物(膣からの異常なおりもの)などが挙げられます。男性では、尿道炎や精巣上体炎の症状が見られることがあります。
- 下腹部の痛み: マイコプラズマ感染により、下腹部の痛みや不快感が生じることがあります。
これらの症状が現れた場合、早期に医療機関を受診し、性病検査を受けることが重要です。性病検査は、感染の早期発見と適切な治療につながります。
マイコプラズマ感染の重要性と性病検査の必要性
マイコプラズマ感染は、無症状であることが多く、感染者が自覚症状を持たない場合でも他の人に感染を広げる可能性があります。また、未治療のままでいると、合併症や他の性感染症との併発リスクが高まることがあります。
性病検査の重要性を理解し、定期的な検査を行うことは自己とパートナーの健康を守るために重要です。性病検査を受けることで、早期発見と適切な治療が可能となり、感染の予防や合併症のリスクを減らすことができます。
また、近年では自宅で利用できる性病検査 STDチェッカーも登場しています。STDチェッカーはプライバシーを守りながら、自宅で簡単に性病検査ができる便利な方法です。指示に従ってサンプルを採取し、郵送で検査結果を受け取ることができます。自宅での検査なので、病院への訪問や面倒な手続きの必要性を軽減し、性病検査のハードルを下げることができます。
まとめ
マイコプラズマ感染は、性的接触によって広まる性病の一種です。しかし、多くの場合は無症状であるため、自覚症状がなくても感染者は他の人に感染を広げる可能性があります。そのため、定期的な性病検査の受診が重要です。
性病検査は、感染の早期発見と適切な治療につながります。自宅で利用できる性病検査 STDチェッカーを活用することで、プライバシーを守りながら簡便な検査が可能です。正確な情報を持ち、性病予防に積極的な行動を取りましょう。自己とパートナーの健康を守るために、定期的な性病検査を受けることをおすすめします。

コメント